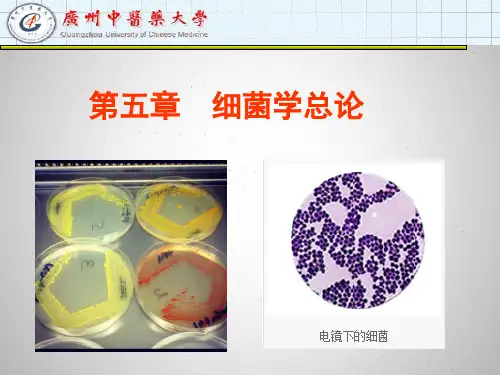

细菌学总论及答案
- 格式:doc
- 大小:32.02 KB
- 文档页数:12

第一章细菌学总论第一节细菌的形态结构细菌(bacterium)是属原核生物界(prokaryotae)的一种单细胞微生物,有广义和狭义两种范畴。
广义上泛指各类原核细胞型微生物,包括细菌、放线菌、支原体、衣原体、立克次体、螺旋体。
狭义上则专指其中数量最大、种类最多、具有典型代表性的细菌,是一种具有细胞壁的属于原核细胞型的单细胞微生物,其个体微小、形态简单,其结构略有分化,具有DNA和RNA,主要靠二裂法繁殖,并可在人工培养基上生长繁殖。
狭义的细菌是本章讨论的对象。
它们形体微小,结构简单,具有细胞壁和原始核质,无核仁和核膜,除核糖体外无其他细胞器。
了解细菌的形态和结构对研究细菌的生理活动、致病性和免疫性,以及鉴别细菌、诊断疾病和防治细菌性感染等均有重要的理论和实际意义。
一、细菌的大小与形态(一)细菌的大小1、观察细菌最常用的仪器是光学显微镜,其大小可以用测微尺在显微镜下进行测量,一般以微米(μm)为单位。
不同种类的细菌大小不一,同一种细菌也因菌龄和环境因素的影响而有差异。
2、细菌个体的大小,以生长在适宜温度和培养基中的年青培养物为标准;细菌的大小是相对稳定,而且具有种的特征。
3、常见的畜禽病原菌多在几个μm之间:球菌:0.5~2μm杆菌用长和宽测量:较大的杆菌长3~8μm,宽1~1.25μm中等大的杆菌长2~3μm,宽0.5~1μm小杆菌长0.7~1.5μm,宽0.2~0.4μm螺旋状菌以其两端的直线距离作长度,一般在2~20μm之间,宽0.4~0.2μm (二)细菌的形态细菌按其外形,主要有球菌、杆菌和螺形菌三大类。
1、球菌(coccus)多数球菌直径在1μm左右,外观呈圆球形或近似球形。
由于繁殖时细菌分裂平面不同和分裂后菌体之间相互粘附程度不一,可形成不同的排列方式,这对一些球菌的鉴别颇有意义。
(1)双球菌(diplococcus):在一个平面上分裂,分裂后两个菌体成对排列,如脑膜炎奈瑟菌、肺炎链球菌。




微生物概述与细菌总论测试题1.下列微生物中,属于非细胞型微生物的是: [单选题] *A.立克次体B.真菌C.衣原体D.病毒(正确答案)E.螺旋体2.细胞核的分化程度高,有核膜和核仁;胞质内细胞器完整的微生物是: [单选题] *A.立克次体B.真菌(正确答案)C.衣原体D.病毒E.螺旋体3.细菌属于原核细胞型微生物的主要依据是 [单选题] *A.单细胞,结构简单B.原始核、细胞器不完善(正确答案)C.二分裂方式繁殖D.有细胞壁E. 对抗生素敏感4.有关原核细胞型微生物错误的描述是 [单选题] *A.无核质(正确答案)B.无核膜和核仁C.细胞器不完善D.具有胞浆膜E.仅有核质、无核的形态5.用来测量细菌大小的单位是 [单选题] *A.cmB.mmC.μm(正确答案)D.nmE.pm6.下列哪种结构不是细菌的基本结构 [单选题] *A.细胞壁B.芽胞(正确答案)C.细胞膜D.细胞质E.核质7.细菌细胞壁的主要成分是 [单选题] *A.蛋白质B.磷脂C.磷壁酸D.肽聚糖(正确答案)E.脂多糖8.G—菌细胞壁内不具有的成分是 [单选题] *A.肽聚糖B.磷壁酸(正确答案)C.脂蛋白D.脂多糖E.外膜9.G+菌细胞壁内特有的成分是 [单选题] *A.肽聚糖B.脂蛋白C.外膜D. 脂多糖E.以上均不是(正确答案)10.维持细菌固有形态的结构是 [单选题] *A.细胞壁(正确答案)B. 细胞膜C.荚膜D. 芽胞E.细胞质11.L型细菌是 [单选题] *A.细胞壁缺陷的细菌(正确答案)B.无核质的细菌C.细胞膜缺陷的细菌D. 质粒丢失的细菌E.无致病力的细菌12.青霉素类抗菌素导致细菌死亡的机制是 [单选题] *A.破坏磷壁酸B.损伤细胞膜C.干扰核糖体抑制菌体蛋白合成D.裂解肽聚糖中N-乙酰葡糖胺和N-乙酰胞壁酸之间的β糖苷键E.抑制肽聚糖中四肽侧链上D-丙氨酸和五肽桥之间的联接(正确答案)13.溶菌酶导致细菌死亡的机制是 [单选题] *A.破坏磷壁酸B.损伤细胞膜C.干扰核糖体抑制菌体蛋白合成D.裂解肽聚糖中N-乙酰葡糖胺和N-乙酰胞壁酸之间的β糖苷键(正确答案)E.抑制肽聚糖中四肽侧链上D-丙氨酸和五肽桥之间的联接14.细胞壁的功能不应包括 [单选题] *A. 维持细菌固有形态B.保护细菌抵抗低渗环境C.具有免疫原性D.具有抗吞噬作用(正确答案)E.参与菌体内外物质的交换15.G—菌对青霉素、溶菌酶不敏感,其原因是 [单选题] *A.细胞壁含肽聚糖少,其外侧还有外膜层保护(正确答案)B.细胞壁含脂多糖较多C.细胞壁缺乏磷壁酸D.细胞壁含脂类AE.以上均是16.有关G+菌细胞壁的特点不正确的是 [单选题] *A.主要成分为肽聚糖B.含有磷壁酸C.对青霉素敏感D.含有大量脂多糖(正确答案)E.易被溶菌酶裂解17.细菌缺乏下列哪种结构在一定条件下仍可存活 [单选题] *A.细胞壁(正确答案)B.细胞膜C.细胞质D.核质E.以上均可18.关于细菌的核质,错误的描述是 [单选题] *A.具有成形的核(正确答案)B.为双链DNA分子C.是细菌生命活动必需的遗传物质D.无核膜E.无核仁19.细菌的特殊结构不包括 [单选题] *A.芽胞B.荚膜C.鞭毛D.质粒(正确答案)E.菌毛20.下列哪种结构与细菌的致病力无关 [单选题] *A.磷壁酸(正确答案)B.荚膜C.鞭毛D.普通菌毛E.以上均不是21.有关质粒的描述哪项是错误的 [单选题] *A.细菌生命活动不可缺少的基因(正确答案)B.为细菌染色体以外的遗传基因C.具有自我复制传给子代的特点D.可从一个细菌转移给另一个细菌E.可自行丢失22.有关荚膜的错误描述是 [单选题] *A.一般在动物体内或含有血清或糖的培养基中形成B.可增强细菌对热的抵抗力(正确答案)C.化学成分可以是多糖,也可以是多肽等D.具有粘附作用E.具有抗吞噬作用23关于菌毛的叙述,下列哪一项是错误的 [单选题] *A.多见于革兰氏阴性菌B.分为普通菌毛和性菌毛C.用普通光学显微镜不能观察D.是细菌的运动器官(正确答案)E.普通菌毛与细菌的致病力有关24.下列哪项不是性菌毛的特点 [单选题] *A.仅见于少数革兰阴性菌B.数目少,有1~4根C.比普通菌毛长而粗D.由F质粒编码E.与细菌的致病性密切相关(正确答案)25.芽胞不是细菌的繁殖方式是因为 [单选题] *A.芽胞只在机体外形成(正确答案)B.芽胞对外界抵抗力强C.并非所有的细菌都能产生芽胞D.一个芽胞发芽只能生成一个菌体,一个细菌的繁殖体也只能形成一个芽胞E.以上均是26. 正常人体无菌的部位是 [单选题] *A.外耳道B.小肠C. 胆囊(正确答案)D.眼结膜E.尿道口27. 有正常菌群的部位 [单选题] *A.胃、肠道、腹腔B.鼻咽腔、脑脊液、眼结膜C.胆囊、肝实质、十二指肠D.尿道、口腔、胃(正确答案)E.皮肤、粘膜、淋巴液28. 杀灭物体上所有微生物(包括细菌芽胞在内)的方法 [单选题] *A. 消毒B. 灭菌(正确答案)C. 无菌D. 抑菌E. 防腐29. 防腐的含义是 [单选题] *A. 杀灭物体上所有微生物B. 杀灭物体上的病原微生物C. 使物体上无活菌存在D. 杀死含芽胞的细菌E. 抑制微生物生长繁殖(正确答案)30. 无菌的含义 [单选题] *A. 杀灭物体上所有微生物B. 杀灭物体上的病原微生物C. 使物体上无活菌存在(正确答案)D. 杀死含芽胞的细菌E. 抑制微生物生长繁殖31. 致病菌侵入宿主体后,只在机体局部生长繁殖,其产生的毒素入血,引起全身中毒症状称为 [单选题] *A.菌血症B.败血症C.毒血症(正确答案)D.脓毒血症E.内毒素血症32. 高压蒸汽灭菌法灭菌需要的条件是 [单选题] *A. 121.3℃,15~20分钟(正确答案)B. 100℃,15~20分钟C. 120℃,10分钟D. 121.3℃,10分钟E. 100℃,20分钟33. 用于耐高温、耐湿等物品的最佳灭菌方法是 [单选题] *A. 高压蒸汽灭菌法(正确答案)B. 煮沸法C. 间歇蒸汽灭菌法D. 流动蒸汽灭菌法E. 巴氏消毒法34. 适用于物体表面和空气灭菌的方法是 [单选题] *A. 干热灭菌法B. 湿热灭菌法C. 紫外线灭菌法(正确答案)D. 电离辐射灭菌法E. 超声波杀菌法35. 紫外线杀菌的最佳波长是 [单选题] *A. 200~300nmB. 260~266nm(正确答案)C. 300~365nmD. 350~400nmE. 400~500nm36.下列哪项不是热力灭菌的机制 [单选题] *A. 使菌体蛋白质变性B. 使菌体蛋白质凝固(正确答案)C. 使细菌核酸降解D. 使细菌胞质膜损伤E. 使细菌电解质降解37.目前主要用于牛乳消毒的方法是 [单选题] *A. 巴氏消毒法(正确答案)B. 煮沸法C. 流动蒸气消毒法D. 间歇蒸气灭菌法E. 高压蒸气灭菌法38. 下列哪种方法能最有效杀死芽胞 [单选题] *A.干热灭菌法B.巴氏消毒法C.高压蒸气灭菌法(正确答案)D.间歇灭菌法E.煮沸法39.观察细菌动力最常使用的培养基是 [单选题] *A.液体培养基B.半固体培养基(正确答案)C.血琼脂平板培养基D.巧克力色琼脂平板培养基E.厌氧培养基40.下列哪项不是细菌生长繁殖的基本条件? [单选题] *A.充足的营养B.合适的酸碱度C.适宜的温度D.必需的气体E.充足的光线(正确答案)41.细菌生长繁殖的方式是: [单选题] *A.有性繁殖B.二分裂法(正确答案)C.形成孢子D.有丝分裂E.复制42.多数细菌繁殖一代所需的时间(代时)为 [单选题] *A.10~20分钟B.20~30分钟(正确答案)C.30~40分钟D.1小时E.2小时43.化脓性细菌侵入血流后,在其中大量繁殖,并通过血流扩散至宿主体的其他组织器官,产生新的化脓性病灶称为 [单选题] *A.菌血症C.毒血症D.脓毒血症(正确答案)E.内毒素血症44.下列哪种物质不是细菌合成代谢产物 [单选题] *A.内毒素(正确答案)B.外毒素C.抗生素D.抗毒素E.细菌素45.关于热原质的叙述,下列哪种是错误的? [单选题] *A.多由革兰阴性菌产生,是细胞壁中的脂多糖B.可被高压蒸气灭菌法破坏(正确答案)C.吸附剂和特殊石棉滤板可除去液体中的大部分热原质D.注入人体或动物体内可引起发热反应E.蒸馏法除去热原质效果最好46.大多数有致病作用的细菌是 [单选题] *A.专性厌氧菌B.专性需氧菌C.微需氧菌D.兼性厌氧菌(正确答案)E.以上均不是47. BCG是有毒牛型结核分枝杆菌经哪种变异形成的? [单选题] *B.结构变异C.毒力变异(正确答案)D.耐药性变异E.菌落变异48. 关于质粒的叙述,下列哪项是错误的 [单选题] *A.是细菌染色体外的遗传物质B.能在胞浆中自行复制C.可自行丢失与消除D.是细菌生命活动所必需的结构(正确答案)E.可在细菌间转移49.关于外毒素的叙述,哪项是错误的? [单选题] *A.由活菌释放到菌体外的一种蛋白质B.主要由G+菌产生,少数G-菌也能产生C.性质稳定,耐热(正确答案)D.毒力强E.抗原性强50.类毒素是 [单选题] *A.抗毒素经甲醛处理后的物质B.内毒素经甲醛处理后脱毒而保持抗原性的物质C.外毒素经甲醛处理后脱毒而保持抗原性的物质(正确答案)D.细菌素经甲醛处理后的物质E.外毒素经甲醛处理后脱毒,改变抗原性的物质。

医学微生物学(第六版)细菌学总论(9学时)绪论(0.5学时)P1一、微生物(Microorganism)(一)定义:微生物是一群形体非常微小、结构简单、肉眼不能直接看见的微小生物。
它们体积微小、结构简单,必须借助光学显微镜放大上千倍,或电子显微镜放大几万倍才能看到。
微生物虽然微小,但具有一定的形态结构和生理功能,且繁殖迅速,适应环境能力强,因而广泛分布于自然界。
(二)种类:微生物按细胞结构特点不同,分为三种类型1、非细胞型(acellular)微生物:无典型的细胞结构,体积非常微小,能通过除菌滤器,结构中仅有核酸和蛋白质,缺乏产生能量的酶系统,只能在活细胞内生长繁殖,病毒为其代表。
近来又发现结构中没有核酸只有蛋白质构成的朊粒。
2、原核细胞型(Prokaryote)微生物:具有细胞的基本结构,但细胞的分化程度较低,仅有原始的核质,无核膜、核仁,胞浆内缺乏完善的细胞器,只有核糖体,包括两菌、四体,细菌、放线菌、支原体、衣原体、立克次体、螺旋体。
3、真核细胞型(eukaryote)微生物:有完整的细胞结构,细胞核的分化程度高,有核膜核仁,胞浆内有完整的细胞器,具有这些细胞结构特点的称真核细胞型微生物,如真菌。
自然界中的微生物,种类多,繁殖快,数量大,而且分布极其广泛,土壤、水、空气中都有,甚至在人和动植物体表以及人和动物与外界相通的腔道中都有微生物存在。
但绝大多数微生物对人类和动植物的生存是无害、甚至是必须的,只有部分微生物能引起人和动物患病,这些具有致病性的微生物称为病原微生物,是医学微生物学研究的对象。
二、微生物学发展史(自学)三、医学微生物学是一门重要的医学基础学科。
研究范畴:1、研究各种病原微生物的生物学特性,即形态、结构、生命活动规律,遗传变异性;2、病原微生物与机体的相互关系,包括:微生物的致病性,如何致病机体的免疫性,如何防病3、疾病的诊断、预防和治疗的原理及方法。
课程内容:细菌学总论9学时细菌学各论9学时病毒及其他微生物18学时第一章细菌的形态与结构(2.5学时)P5-16细菌属于原核细胞型微生物,具有相对恒定的形态结构,了解细菌形态结构的特点不仅有助于鉴别细菌,诊断疾病,而且对研究细菌的致病性和免疫性也有重要意义。

医学微生物学――细菌学总论一、选择题1.与动物细胞结构相比较,细菌所特有的一种重要结构是A.核糖体(核蛋白体)B.线粒体C.高尔基体D.细胞膜E.细胞壁2.与细菌的运动有关的结构是A.鞭毛B.菌毛C.纤毛D.荚膜E.轴丝3.与内毒素有关的细菌结构是A.外膜B.核膜C.线粒体膜D.荚膜E.细胞膜4.在细菌生物学特性中,与芽孢有关的是A.抗吞噬B.产生毒素C.耐热D.粘附于感染部位E.侵袭力5.细菌的“核质以外遗传物质”是指A.mRNA.B.核蛋白体C.质粒D.异染颗粒E.性菌毛6.细菌归属于A.动物界B.植物界C.原生生物界D.真菌界E.原核生物界7.大多数细菌的代时,所需时间为A.5~10minB.20~30minC.60~80minD.18~24hE.33h8.细菌生长繁殖的方式是A.二分裂B.有丝分裂C.孢子生殖D.复制E.出芽9.为了从患者的标本中分离到单个菌落,应将标本接种到A.液体培养基中B.半固体培养基中C.固体培养基中D.含抗生素的培养基中E.高渗透压培养基中10.细菌在代谢过程中,可以合成的产物是A.抗毒素B.干扰素C.生长因子D.热源质E.类毒素11.产生毒素与噬菌体有关的细菌是A.大肠埃希氏菌B.白喉棒状杆菌C.霍乱弧菌D.产气荚膜梭菌E.破伤风梭菌12.前噬菌体是指A.已整合到宿主菌染色体上的噬菌体基因组B.尚未感染细菌的游离噬菌体C.进入宿主菌体内的噬菌体D.成熟的子代噬菌体E.尚未完成装配的噬菌体13.不是噬菌体特性的一项为A.专性细胞内寄生B.具备细胞结构C.由衣壳和核酸组成D.个体微小E.以复制方式增殖14.下列有关噬菌体的描述,错误的一项是A.噬菌体基因可与细菌DNA发生整合B.可用噬菌体进行细菌鉴定C.细菌带有噬菌体后发生的性状改变,均称为溶源性转换D.噬菌体溶解细菌后,可形成噬斑E.可用噬菌体作载体进行分子生物学研究15.有关质粒的叙述,不正确的为A.质粒是细菌核质以外的遗传物质B.质粒是细菌必备结构C.质粒不是细菌必备结构D.质粒是双股环状DNAE.质粒可独立存在于细菌体内16.与细菌耐药性有关的遗传物质是A.异染颗粒B.毒性噬菌体C.质粒D.细菌染色体E.性菌毛17.转导与溶原性转换的共同点是A.以噬菌体为载体B.转移的遗传物质为供体菌的DNA C.有关的噬菌体均为缺陷型D.可由雌性菌变为雄性菌E.通过性菌毛连接沟通18.与细菌致病性无关的代谢产物是A.毒素B.血浆凝固酶C.热原质D.细菌素E.透明质酸酶19.利于细菌在体内扩散的物质是A.菌毛B.荚膜C.M蛋白D.血浆凝固酶E.透明质酸酶20.内毒素的毒性成分是A.特异性多糖B.脂多糖C.核心多糖D.脂质AE.脂蛋白21.关于内毒素的叙述,错误的是A.来源于革兰氏阴性菌B.能用甲醛脱毒制成类毒素C.其化学成分是脂多糖D.性质稳定,耐热E.菌体死亡裂解后才释放出来22.外毒素的特点之一是A.由革兰氏阴性菌产生B.可制备成类毒素C.多为细菌裂解后释放D.化学组成是脂多糖E.耐热23.以神经毒素致病的细菌是A.伤寒沙门氏菌B.霍乱弧菌C.肉毒梭菌D.乙型溶血性链球菌E.脑膜炎奈瑟氏菌24.抑制细胞蛋白合成的外毒素是A.白喉毒素B.耐热肠毒素C.霍乱肠毒素D.破伤风痉挛毒素E.不耐热肠毒素25.决定微生物毒力的因素,不包括A.微生物的表面物质B.细菌分泌的酶C.内毒素和外毒素D.进入机体的微生物数量E.微生物繁殖对宿主的危害26.与细菌侵袭力无关的表面结构是A.荚膜B.普通菌毛C.性菌毛D.鞭毛E.磷壁酸27.不属于正常体液与组织中的抗菌物质是A.补体B.溶菌酶C.抗生素D.防御素E.白细胞介素28.构成机体固有免疫的因素,不包括A.皮肤与黏膜的屏障作用B.自然杀伤细胞(NK细胞)C.细胞因子如白介素、干扰素等D.正常组织和体液中抗菌物质的作用E.乳汁中SIgA的作用29.应用细菌的生化反应进行鉴定细菌的根据是A .酶活性不同B.酶含量的差异C.毒素的种类D.毒素含量的差异E.分解代谢产物的不同30.只需经过镜检可以确诊的细菌感染是A.鼠疫菌感染B.布氏菌感染C.结核菌感染D.百日咳菌感染E.痢疾菌感染31.为提高镜检率需对标本进行浓缩处理的细菌是A.炭疽杆菌B.结核杆菌C.痢疾志贺氏菌D.铜绿假单胞菌E.幽门螺杆菌32.采集双份血清对细菌感染做出诊断的方法是A.特异性抗体检查法B.分子生物学法C.生物化学法D.药敏试验法E.动物试验法33.采集细菌标本要避免杂菌污染应注意A.标本采集部位B.标本采集时间C.标本采集方式D.标本采集温度E.标本采集的无菌操作34.药敏试验的主要目的,不在于A.测定药物体外杀菌作用B.进行耐药菌株筛选C.分析药物成分D.指导临床用药E.监测耐药菌流行趋势35.病原性真菌的培养应选用A.沙保氏培养基B.罗氏培养基C.亚碲酸钾培养基D.巧克力色培养基E.碱性培养基36.下列培养微生物的方法中,不适于培养动物病毒的方法是A.鸡胚培养B.人工合成培养基培养C.二倍体细胞培养D.器官培养E.动物培37.不能作为病毒在细胞内生长繁殖指标的一项是A.致细胞病变作用B.红细胞凝集C.干扰现象D.细胞培养液变混浊E.细胞培养液PH改变38.下列分子生物学实验中,检测病毒蛋白的方法是A.原位杂交B.点杂交C.Southern blotD.Western blotE.Northern blot二、名词解释1.plasmid2.L-form of bacterium 3.colony 4.endotoxin 5.exotoxin 6.transformation 7.transduction8.conjugation9.virulent phage10.opportunistic pathogen11.septicemia三、问答题1.试比较革兰氏阳性(G+)菌与革兰氏阴性(G-)菌细胞壁结构的特征。

第十章细菌学总论第一节细菌的形态、结构与分类参考答案二.填空题。
1.(抗吞噬作用,粘附作用,抗有害物质的损伤作用)2.(生物膜)3.(脂质A,核心多糖,特异多糖)4.(聚糖骨架,四肽侧链) 5.(芽胞) 6.(染色体,质粒,质粒)7.(性菌毛,细菌粘附,传递遗传物质) 8.(鞭毛,荚膜,芽胞,菌毛)9.(细胞壁,细胞膜) 10.(球菌,杆菌)11.(肽聚糖,磷壁酸,脂多糖) 12.(壁磷壁酸,膜磷壁酸)13.(聚糖骨架,四肽侧链,五肽交联桥) 14.(脂质双层,脂蛋白,脂多糖)15.(革兰阴性) 16.(D-丙氨酸,五肽桥,肽聚糖)17.(核糖体,70S)18.(50S,30S,蛋白质)19.(休眠,强,繁殖,弱) 20.(细胞壁)三.名词解释。
1.细菌L型:细菌细胞壁的肽聚糖受到理化或生物因素的直接破坏或合成被抑制,造成其不同程度的缺损,这种细胞壁受损的细菌在高渗环境下仍可存活的细菌称为细菌L型。
2.芽胞:某些细菌的繁殖体,在一定条件下,由胞浆脱水浓缩,在菌体内形成一个折光性强的圆形或卵圆形小体叫芽胞,芽胞对理化因素具有强大抵抗力。
3.荚膜:某些细菌能分泌黏液状物质包围于细胞壁外,形成一层和菌体界限分明、不易着色的透明圈。
主要由多糖组成,少数细菌为多肽,其主要的功能是抗吞噬作用,并具有抗原性。
4.肽聚糖:是细菌细胞壁的主要化学成分,为原核生物所特有的物质。
G+菌的肽聚糖由聚糖骨架、四肽侧链和五肽交联桥三部分组成。
G-菌的肽聚糖由聚糖骨架和四肽侧链两部分组成。
5.脂多糖(LPS):是G-菌的内毒素,由类脂A、核心多糖和特异性多糖组成。
类脂A是内毒素的毒性部分和主要成分。
6.异染颗粒:某些细菌用异染颗粒染色法染色时,甲苯胺蓝可同该菌细胞浆中的多聚磷酸盐颗粒结合,使颗粒染成与菌体不同的红紫色,这一现象称为异染现象,具有异染现象的颗粒叫异染颗粒。
四.判断改错题。
1.(×)磷壁酸2.(×)一个繁殖体3.(√)4.(×)细胞壁缺陷5.(×)无固醇类物质6. (×)和五肽交联桥7.(√)五.简答题。
【名词解释】菌种species 细菌分类的基本单位,彼此间有70%及以上的DNA同源性,同时也具有5℃或更低的Tm值的细菌群体。
其中差异明显的称为亚种,差异较小的称为型菌属genus 特性相近,关系密切的若干菌种组成一个菌属菌株strain 对不同来源的同一菌种的细菌称为该菌的不同菌株前噬菌体prophage 温和噬菌体的基因组整合于宿主菌基因组中,这种整合在细菌染色体上的噬菌体基因为~。
前噬菌体可随细菌染色体的复制而复制,并通过细菌的分裂传给下一代,但不引起细菌的裂解溶原性细菌Lysogenicbacterium 带有前噬菌体的细菌,它处于噬菌体免疫状态,能使得噬菌体不能吸附于细菌表面的特异性受体溶原性lysogeny 前噬菌体偶尔可以自发地或在某些理化和生物因素的诱导下脱离宿主菌染色体而进入溶菌周期,导致细菌裂解。
温和噬菌体具有的这种产生成熟子代噬菌体颗粒和裂解宿主菌的潜在能力溶源性转换Lysogenicconversion 某些前噬菌体可导致细菌基因型和性状发生改变,如β-棒状杆菌噬菌体感染无毒的白喉棒状杆菌获得了产生白喉毒素的能力细菌致病岛Pathogenicisland 病原菌基因组中存在编码与细菌毒力或致病性相关因子的外源DNA片段,其两侧常有重复序列、插入序列或tRNA。
其GC含量往往低于细菌基因组的平均GC含量不相容性incompatibility 因结构相似并密切相关的质粒不能稳定共存于一个宿主菌的现象,与宿主范围、复制部位和复制调控机制有关F质粒(致育质粒)Fertilityplasmid编码性菌毛,介导细菌间质粒的接合传递耐药质粒Resistantplasmid 编码产物与多种抗菌药物和重金属的抗性有关的质粒,其中可通过接合方式进行基因传递的为接合性耐药质粒,又称R 质粒;反之称为r质粒转座元件Transposableelement 一类不依赖于同源重组即可在细菌或其他生物的基因组(染色体、质粒、噬菌体基因组)中改变自身位置的独特DNA 序列,又称为跳跃基因,可以导致基因的不稳定和高突变率。
细菌学总论一、选择题【A型题】1.证明细菌具有鞭毛结构的常用方法是:EA.革兰染色法B.抗酸染色法C.普通琼脂培养法D.液体培养法E.半固体培养法2.革兰染色法在临床上常用于: BA.鉴别细菌的血清型别B.协助临床选择用药C.诊断疾病D.解释发病机制E.判定细菌的免疫性3.测量细菌的常用单位是:BA.mmB.μmC.nmD.pmE.4.不属于细菌的基本结构的是:DA.细胞壁B.细胞膜C.细胞浆D.细胞器E.核质5.细菌细胞壁的最主要成分是: B A.脂类B.蛋白质C.糖类D.脂蛋白E.***聚糖6.不属于细胞基本结构的是: A A.鞭毛B.中介体C.细胞膜D.核糖体E.核质7.青霉素抗菌作用的机理是: A A.干扰菌细胞壁的合成B.破坏菌细胞壁上的磷壁酸C.干扰菌细胞蛋白质的合成D.破坏菌细胞膜的通透性E.破坏菌细胞壁的多糖骨架8.溶菌酶的杀菌机理是:EA.干扰菌细胞壁交联桥的合成B.干扰二氨基庚二酸的活性C.破坏聚糖骨架上四***侧链的连接D.干扰菌细胞核质的活性E.破坏菌壁多糖骨架β-1、4键的连接9.关于L型细菌叙述错误的是:C A.由于细胞壁缺陷常呈多形态B.染色体不易着色C.无致病力D.常规细菌学检查多呈阴性E.除去诱导因素可回复成原来的细菌10.质粒是细胞的:AA.染色体以外DNAB.核质RNAC.储存高能的胞浆颗粒D.胞浆中rRNAE.中介体11.关于菌毛叙述错误的是:A A.是细菌的运动器官B.分为普通菌毛和性菌毛C.成分是蛋白质D.普通菌毛与细菌的致病性有关E.普通光学显微镜下不能看见12.细菌的革兰染色性不同主要是因为:D A.形态不同B.营养需要不同C.生理功能不同D.细菌细胞壁结构不同E.致病性不同13.细菌学形态学检查中最常用染色方法是: E A.抗酸性染色法B.特殊染色法C.暗视野墨汁染色法D.美兰单染色法E.革兰染色法14.细菌的繁殖形式是:DA.接合B.裂殖C.胞子D.二分裂E.复制15.在细菌生长曲线中菌数增加最快的是:B A.迟缓期B.对数期C.稳定期D.衰亡期E.全部生长过程16.有关热原质叙述错误的是:DA.是多数G-菌少数G+菌合成代谢产物B.是G-菌细胞壁中脂多糖C.注入人、动物体可引起发热D.可被121℃20分钟处理破坏E.可经吸负剂、石棉滤板除掉17.下列那种不是细菌的合成代谢产物:EA.色素B.细菌素C.抗生素D.维生素E.抗毒素18.关于噬菌体生物学特性叙述错误的是:BA.是细菌的病毒B.不具有抗原性C.主要成分是核酸和蛋白质D.形态多呈蝌蚪状E.较细菌的抵抗力强19.不产毒的白喉棒状杆菌,携带了β—棒状杆菌噬菌体后便可产生这种现象称为:D A.转导B.转化C.接合D.溶原性转换E.原生质体融合20.病原菌引起疾病的最佳组合是: AA.毒力+侵入门户+细菌数量B.毒素+侵袭力+侵入门户C.侵袭力+细菌数量D.细菌数量+侵袭酶类E.侵入门户+毒素+细菌表面结构21.细菌内毒素的特点下列哪项是错误的: C A.主要由G—菌产生B.化学成分主要是脂多糖C.对人体组织有选择性毒性作用D.可单独激活补体旁路途径E.可使鲎血液变形细胞溶解物凝固。
一、选择题
1.与动物细胞结构相比较,细菌所特有的一种重要结构是A.核糖体(核蛋白体)
B.线粒体
C.高尔基体
.细胞膜 D
.细胞壁E
2.与细菌的运动有关的结构是
.鞭毛 A
B.菌毛
.纤毛C
.荚膜D
.轴丝 E
.与内毒素有关的细菌结构是 3
.外膜A
B.核膜
C.线粒体膜
D.荚膜
E.细胞膜
4.在细菌生物学特性中,与芽孢有关的是
A.抗吞噬
.产生毒素 B
C.耐热
D.粘附于感染部位
E.侵袭力
是指“核质以外遗传物质”5.细菌的
mRNA.A.
B.核蛋白体
.质粒C
.异染颗粒 D
E.性菌毛
6.细菌归属于
A.动物界
.植物界 B
C.原生生物界
D.真菌界
.原核生物界E
7.大多数细菌的代时,所需时间为
A.5~10min
B.20~30min
C.60~80min
D.18~24h
33h E.
8.细菌生长繁殖的方式是
A.二分裂
.有丝分裂B
C.孢子生殖
D.复制
E.出芽
9.为了从患者的标本中分离到单个菌落,应将标本接种到A.液体培养基中
.半固体培养基中B
.固体培养基中 C
D.含抗生素的培养基中
E.高渗透压培养基中
.细菌在代谢过程中,可以合成的产物是10
A.抗毒素
B.干扰素
C.生长因子
D.热源质
.类毒素 E
11.产生毒素与噬菌体有关的细菌是
A.大肠埃希氏菌
.白喉棒状杆菌B
C.霍乱弧菌
.产气荚膜梭菌 D
.破伤风梭菌E
.前噬菌体是指12
A.已整合到宿主菌染色体上的噬菌体基因组
B.尚未感染细菌的游离噬菌体
.进入宿主菌体内的噬菌体C
.成熟的子代噬菌体 D
E.尚未完成装配的噬菌体
13.不是噬菌体特性的一项为
.专性细胞内寄生A
B.具备细胞结构
C.由衣壳和核酸组成
D.个体微小
.以复制方式增殖 E
14.下列有关噬菌体的描述,错误的一项是
A.噬菌体基因可与细菌DNA发生整合
.可用噬菌体进行细菌鉴定 B
C.细菌带有噬菌体后发生的性状改变,均称为溶源性转换D.噬菌体溶解细菌后,可形成噬斑
.可用噬菌体作载体进行分子生物学研究E
.有关质粒的叙述,不正确的为15
A.质粒是细菌核质以外的遗传物质B.质粒是细菌必备结构
C.质粒不是细菌必备结构
D.质粒是双股环状DNA
.质粒可独立存在于细菌体内 E 16.与细菌耐药性有关的遗传物质是
A.异染颗粒
.毒性噬菌体B
C.质粒
D.细菌染色体
E.性菌毛
17.转导与溶原性转换的共同点是A.以噬菌体为载体
B.转移的遗传物质为供体菌的DNA C.有关的噬菌体均为缺陷型
.可由雌性菌变为雄性菌D
E.通过性菌毛连接沟通
.与细菌致病性无关的代谢产物是18 .毒素A
B.血浆凝固酶
C.热原质
.细菌素D
E.透明质酸酶
19.利于细菌在体内扩散的物质是A.菌毛
B.荚膜
.C M蛋白
D.血浆凝固酶
E.透明质酸酶
20.内毒素的毒性成分是
A.特异性多糖
B.脂多糖
C.核心多糖
.脂质A D
.脂蛋白 E
21.关于内毒素的叙述,错误的是A.来源于革兰氏阴性菌
B.能用甲醛脱毒制成类毒素
.其化学成分是脂多糖 C
.性质稳定,耐热 D
.菌体死亡裂解后才释放出来 E .外毒素的特点之一是22
A.由革兰氏阴性菌产生
B.可制备成类毒素
C.多为细菌裂解后释放
.化学组成是脂多糖D
E.耐热
23.以神经毒素致病的细菌是
A.伤寒沙门氏菌
.霍乱弧菌 B
C.肉毒梭菌
.乙型溶血性链球菌 D
E.脑膜炎奈瑟氏菌
24.抑制细胞蛋白合成的外毒素是A.白喉毒素
B.耐热肠毒素
.霍乱肠毒素 C
D.破伤风痉挛毒素
E.不耐热肠毒素
25.决定微生物毒力的因素,不包括
A.微生物的表面物质
B.细菌分泌的酶
C.内毒素和外毒素
.进入机体的微生物数量 D
E.微生物繁殖对宿主的危害
26.与细菌侵袭力无关的表面结构是
A.荚膜
B.普通菌毛
C.性菌毛
D.鞭毛
E.磷壁酸
27.不属于正常体液与组织中的抗菌物质是A.补体
.溶菌酶B
C.抗生素
.防御素 D
.白细胞介素E
.构成机体固有免疫的因素,不包括28
A.皮肤与黏膜的屏障作用
(NK细胞).自然杀伤细胞 B
.细胞因子如白介素、干扰素等 C
D.正常组织和体液中抗菌物质的作用
SIgA的作用.乳汁中 E
29.应用细菌的生化反应进行鉴定细菌的根据是A .酶活性不同
B.酶含量的差异
C.毒素的种类
D.毒素含量的差异
E.分解代谢产物的不同
30 .只需经过镜检可以确诊的细菌感染是
A.鼠疫菌感染
.布氏菌感染B
C.结核菌感染
.百日咳菌感染 D
.痢疾菌感染E
31.为提高镜检率需对标本进行浓缩处理的细菌是A.炭疽杆菌
.结核杆菌 B
C.痢疾志贺氏菌
D.铜绿假单胞菌
E.幽门螺杆菌
.采集双份血清对细菌感染做出诊断的方法是32 .特异性抗体检查法 A
B.分子生物学法
C.生物化学法
D.药敏试验法
E.动物试验法
33.采集细菌标本要避免杂菌污染应注意
A.标本采集部位
.标本采集时间 B
C.标本采集方式
.标本采集温度 D
E.标本采集的无菌操作
34.药敏试验的主要目的,不在于
.测定药物体外杀菌作用 A
B.进行耐药菌株筛选
C.分析药物成分
.指导临床用药 D
.监测耐药菌流行趋势 E
35.病原性真菌的培养应选用
.沙保氏培养基 A
B.罗氏培养基
C.亚碲酸钾培养基
D.巧克力色培养基
E.碱性培养基
36.下列培养微生物的方法中,不适于培养动物病毒的方法是A.鸡胚培养
.人工合成培养基培养 B
C.二倍体细胞培养
D.器官培养
E.动物培
.不能作为病毒在细胞内生长繁殖指标的一项是37
A.致细胞病变作用
B.红细胞凝集
C.干扰现象
D.细胞培养液变混浊
改变E.细胞培养液PH
38.下列分子生物学实验中,检测病毒蛋白的方法是
A.原位杂交
.点杂交B
.CSouthern blot
D.Western blot
E.Northern blot
二、名词解释
plasmid1.
2.L-form of bacterium
3.colony
endotoxin4.
5.exotoxin
transformation6.
7.transduction
conjugation8.
virulent phage9.
10.opportunistic pathogen
11.septicemia
三、问答题
1.试比较革兰氏阳性(G+)菌与革兰氏阴性(G-)菌细胞壁结构的特征。
2.请简述作用于细菌细胞壁肽聚糖的某些抗生素及其抑菌或杀菌作用的机制。
3.根据培养基性质和用途,可将培养基分为几类?每类各举一种常用培养基。
.请列表比较内毒素与外毒素的主要区别。
4
5.进行细菌感染的血清学诊断时,判定结果应注意的问题。
参考答案
一、选择题
C .B 12..A 13.B 14C 6.E 7B.8.A 9.C 10.
D 11A 41.
E 2.A 3..C 5.C ..D 26.C 27B 21.B 22.B 23.C 24.A 25..15B 16.C 17.A 18.D 19E 20.D.D 38.C 35.E 34..A 36.B 37C 3128.E 29.E 30..B 32.A 33
二、名词解释
1.质粒(plasmid),是细菌除核质之外的遗传物质,结构为dsDNA,具有自我复制功能。
它可使细菌获得某些特定性状,如耐药性、毒力等。
有些细菌在某些体内外环境及抗生素等作用下,,型(L-form of bacterium)2.细菌L型。
在适宜条件LLister研究所发现,故称细菌可部分或全部失去细胞壁,此现象首先由型可回复成原细菌型。
下,多数细菌L
,单个细菌在固体培养基上生长繁殖,形成的肉眼可见的细菌集团。
(colony)3.菌落
4.内毒素(endotoxin),即革兰氏阴性菌细胞壁的脂多糖,其毒性成分为类脂A,当菌体死亡裂解后才释放出来。
是由革兰氏阳性菌和少数革兰氏阴性菌在生长代谢过程中释放,外毒素(exotoxin)5.至菌体外、具有选择性毒性作用的蛋白质。
获得新的遗传性状的DNA6.转化(transformation),受体菌直接摄取供体菌游离的
过程。
片段转移到受体菌内,使DNA7.转导(transduction),以噬菌体为媒介,将供体菌受体菌获得新的遗传形状。
,细菌通过性菌毛相互连接沟通,将遗传物质(质粒或染色体8.接合(conjugation) )从供体菌转移给受体菌的过程称为接合。
DNA.。